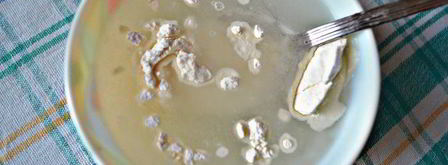
тефтели с грибами в томатном соусе. Шаг 7

Тефтели с грибами в томатном соусе
Рецепт от: athat
- Рецепт: Простой
- Время приготовления: 1 ч 30 мин
- Порций: 6
- Калорий: 103 ккал
- Кухня: Домашняя
Предлагаю вам приготовить очень вкусное, сытное и уютное блюдо для семейного обеда или ужина.
Ингредиенты на
- шампиньоны - 250 г
- сыр - 50 г
- лук репчатый - 1 шт.
- чеснок - 1 зубчик
- рис - ½ стак.
- томатный сок - 1 стак.
- мука - 2 ст.л.
- сметана 20% - 3 ст.л.
- растительное масло - 1 ст.л.
- соль - по вкусу
- сахар - 1 ч.л.
- перец черный свежемолотый - по вкусу
- укроп свежий - 3 веточки
- мясной фарш - 300 г
Как приготовить
-
Нам понадобится 0,5 ст (100г) отварного риса.
-
Подготовьте мясной фарш (у меня свинина + говядина).

-
Измельчите лук, очистите и порежьте грибы, с помощью пресса измельчите чеснок.

-
Сыр твердых сортов (у меня - Джугас) натрите на мелкой терке, укроп мелко порубите. К фаршу добавьте рис, лук с чесноком, грибы, укроп, посолите и поперчите по вкусу.

-
Все хорошо вымешайте. Руки смочите холодной водой и сформируйте из полученного фарша тефтели. Форму для запекания смажьте растительным маслом и выложите в нее тефтели.

-
Для соуса к томатному соку добавьте сахар, сметану и перемешайте, а при необходимости - подсолите.

-
Муку перемешайте с 0,5 стакана холодной воды и хорошо размешайте, чтобы не было комочков. Затем соедините с томатно-сметанной смесью.

-
Тефтели залейте получившимся соусом. Форму с тефтелями накройте фольгой и запекайте в разогретой до 180г духовке в течение 50 мин - 1ч.

-
Готовые тефтели подавайте со спагетти или картофелем, полив обильно томатным соусом и посыпав рубленной зеленью. Приятного вам аппетита!


Фото тефтелей с грибами в томатнома соусе.

Тефтели с моцареллой в томатном соусе
Тефтели
Тефтели в сливочно-томатном соусе
Тефтели
Тефтели в сметанно-томатном соусе
Тефтели
Обсуждение
Столько нового узнала про тефтели с грибами в томатном соусе!
Спасибо!!
Athat, спасибо за прекрасный рецепт! тефтели с грибами в томатном соусе всей моей семье очень понравилось!
Все ингредиенты подобраны идеально и друг друга не перебивают, а дополняют.
Вот это ДААААА!!!
Я приготовила тефтели с грибами в томатном соусе для вечеринки с семьёй.
Все мои американские родственники разборчивые в еде.
А тефтели с грибами в томатном соусе не переставали хвалить!
Спасибо за рецепт!
Athat, спасибо.
Вчера попробовала тефтели с грибами в томатном соусе сделать.
Все получилось.
Это, реально, вкуснотища.
Обязательно попробую тефтели с грибами в томатном соусе, это вкусно.
Тефтели с тыквой в томатном соусе
Тефтели
Куриные тефтели в томатном соусе
Тефтели
Рыбные тефтели в томатном соусе
Тефтели